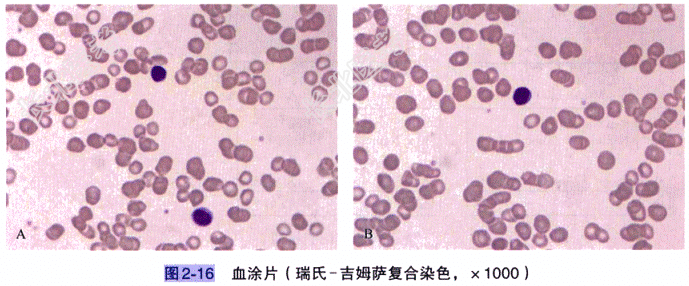

试题详情
- [材料题] 患者,男,63岁。因“间断排酱油色尿,伴乏力1年”入院。患者1年来反复出现间断酱油色尿,伴全身乏力、四肢酸痛,于外院治疗,具体治疗不详,半个月前上述症状再发加重,故就诊于我院。体格检查 无畏寒、发热,无皮肤、牙龈出血,无恶心、呕吐,无尿频、尿急,无腹痛、黄疸,心、肺、肝、脾检查未见异常。辅助检查:(1)常规检查:血常规WBC1.92×10⁹/L,中性粒细胞百分比37.0%,淋巴细胞百分比55.0%,单核细胞百分比8.0%,RBC2.09×10¹²/L,Hb70.0g/L,PLT207×10⁹/L。(2)细胞形态学检查:①血象结果:白细胞数量减少,分类中性粒细胞比例减低,淋巴细胞比例增高(图2-16)。②骨髓象结果:红系增生旺盛,以中、晚幼红细胞为主,可见双核红细胞、炭核红细胞,成熟红细胞可见大小不均,粒系、巨核系增生较差,少量细胞可见形态改变,能否考虑PNH请结合临床,建议做流式细胞学PNH检测明确诊断(图2-17)。③流式细胞学PNH检测结果:见图2-18、图2-19及表2-1。(3)临床诊断:阵发性睡眠性血红蛋白尿(PNH)。

- 简答题1、该案例的诊断依据是什么?
关注下方微信公众号,搜题查看答案

- 简答题2、为什么该患者流式细胞学PNH检测结果中粒细胞的CD59阴性细胞比例大于其红细胞CD59阴性细胞比例?
关注下方微信公众号,搜题查看答案

- 简答题3、流式细胞学PNH检测,标本送检有什么时间要求吗?对结果是否会有影响?
关注下方微信公众号,搜题查看答案

热门试题
- 1、该患者可能的诊断是什么?2、为明确诊
- 1、患者可能的诊断是什么?2、怀疑毒鼠强
- 1、根据患者表现及实验室检查结果,本患者
- 1、在抗栓治疗过程中,主要通过哪些血液学
- 1、根据患者的血常规检查结果,可能考虑疾
- 1、缺铁性贫血临床表现有哪些?2、缺铁性
- 1、该案例的诊断依据是什么?2、慢性粒细
- 1、为什么在DVT的诊断中要检测VEGF
- 1、患者碰伤有血肿出血,且有遗传家族史,
- 1、该患者最可能的诊断是什么?2、符合该
- 1、该患者最可能的诊断是什么?2、患者确
- 1、根据上述情况,你认为应该进行哪些凝血
- 1、血细胞免疫分型在该患者中的应用目的有
- 1、糖化血红蛋白检测中最易受HbF干扰的
- 1、该患者最可能的诊断是什么?2、要确定
- 1、如需了解该患者肝脏合成能力,应测定的
- 1、为明确诊断,应选择的实验室检查有什么
- 1、该患者白细胞减少的原因是什么?2、该
- 1、如果进行骨髓涂片检查,可有什么发现?
- 1、该案例的诊断依据是什么?2、形态学、